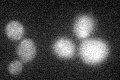
YGR182C

View description
Dubious open reading frame unlikely to encode a protein, based on available experimental and comparative sequence data; partially overlaps the verified ORF TIM13/YGR181W
Localization:
Intensity:
Fold change:
Significance:
-
C’ GFP library in SD

below threshold15.11 -
N' NOP1pr-GFP in SD

N/A0 -
N' TEF2pr-mCherry in SD

N/A0 -
N' NATIVEpr-GFP in SD

N/A0 -
N' TEF2pr-VC and Cyto-VN in SD

N/A0 -
C’ GFP library in SD+DTT

cytosol15.511.02No -
C’ GFP library in SD+H2O2
cytosol17.941.18No -
C’ GFP library in Starvation Media

cytosol18.691.23No -
C’ GFP library on the background of Pup2-DaMP

N/A -
C’ GFP library on the background of CCT mutant

N/A0N/AYes
